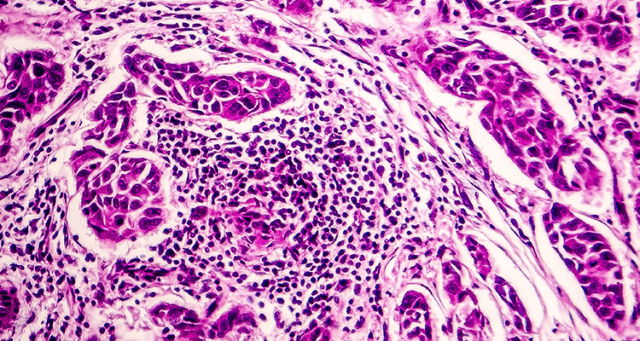
Le système lymphatique

Le système lymphatique : allié majeur de la régénération cellulaire et de l’immunité
Souvent éclipsé par le système circulatoire sanguin, le système lymphatique est pourtant le gardien de notre milieu intérieur. À l’Institut Fascia Education, nous intégrons cette dimension physiologique comme un pilier fondamental, que ce soit pour la revitalisation du visage ou l’accompagnement postural en Rose Pilates.